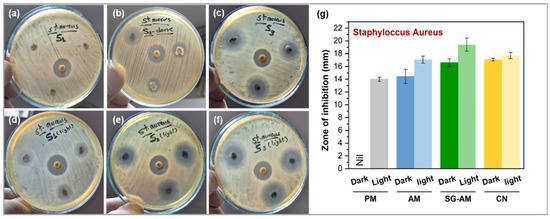
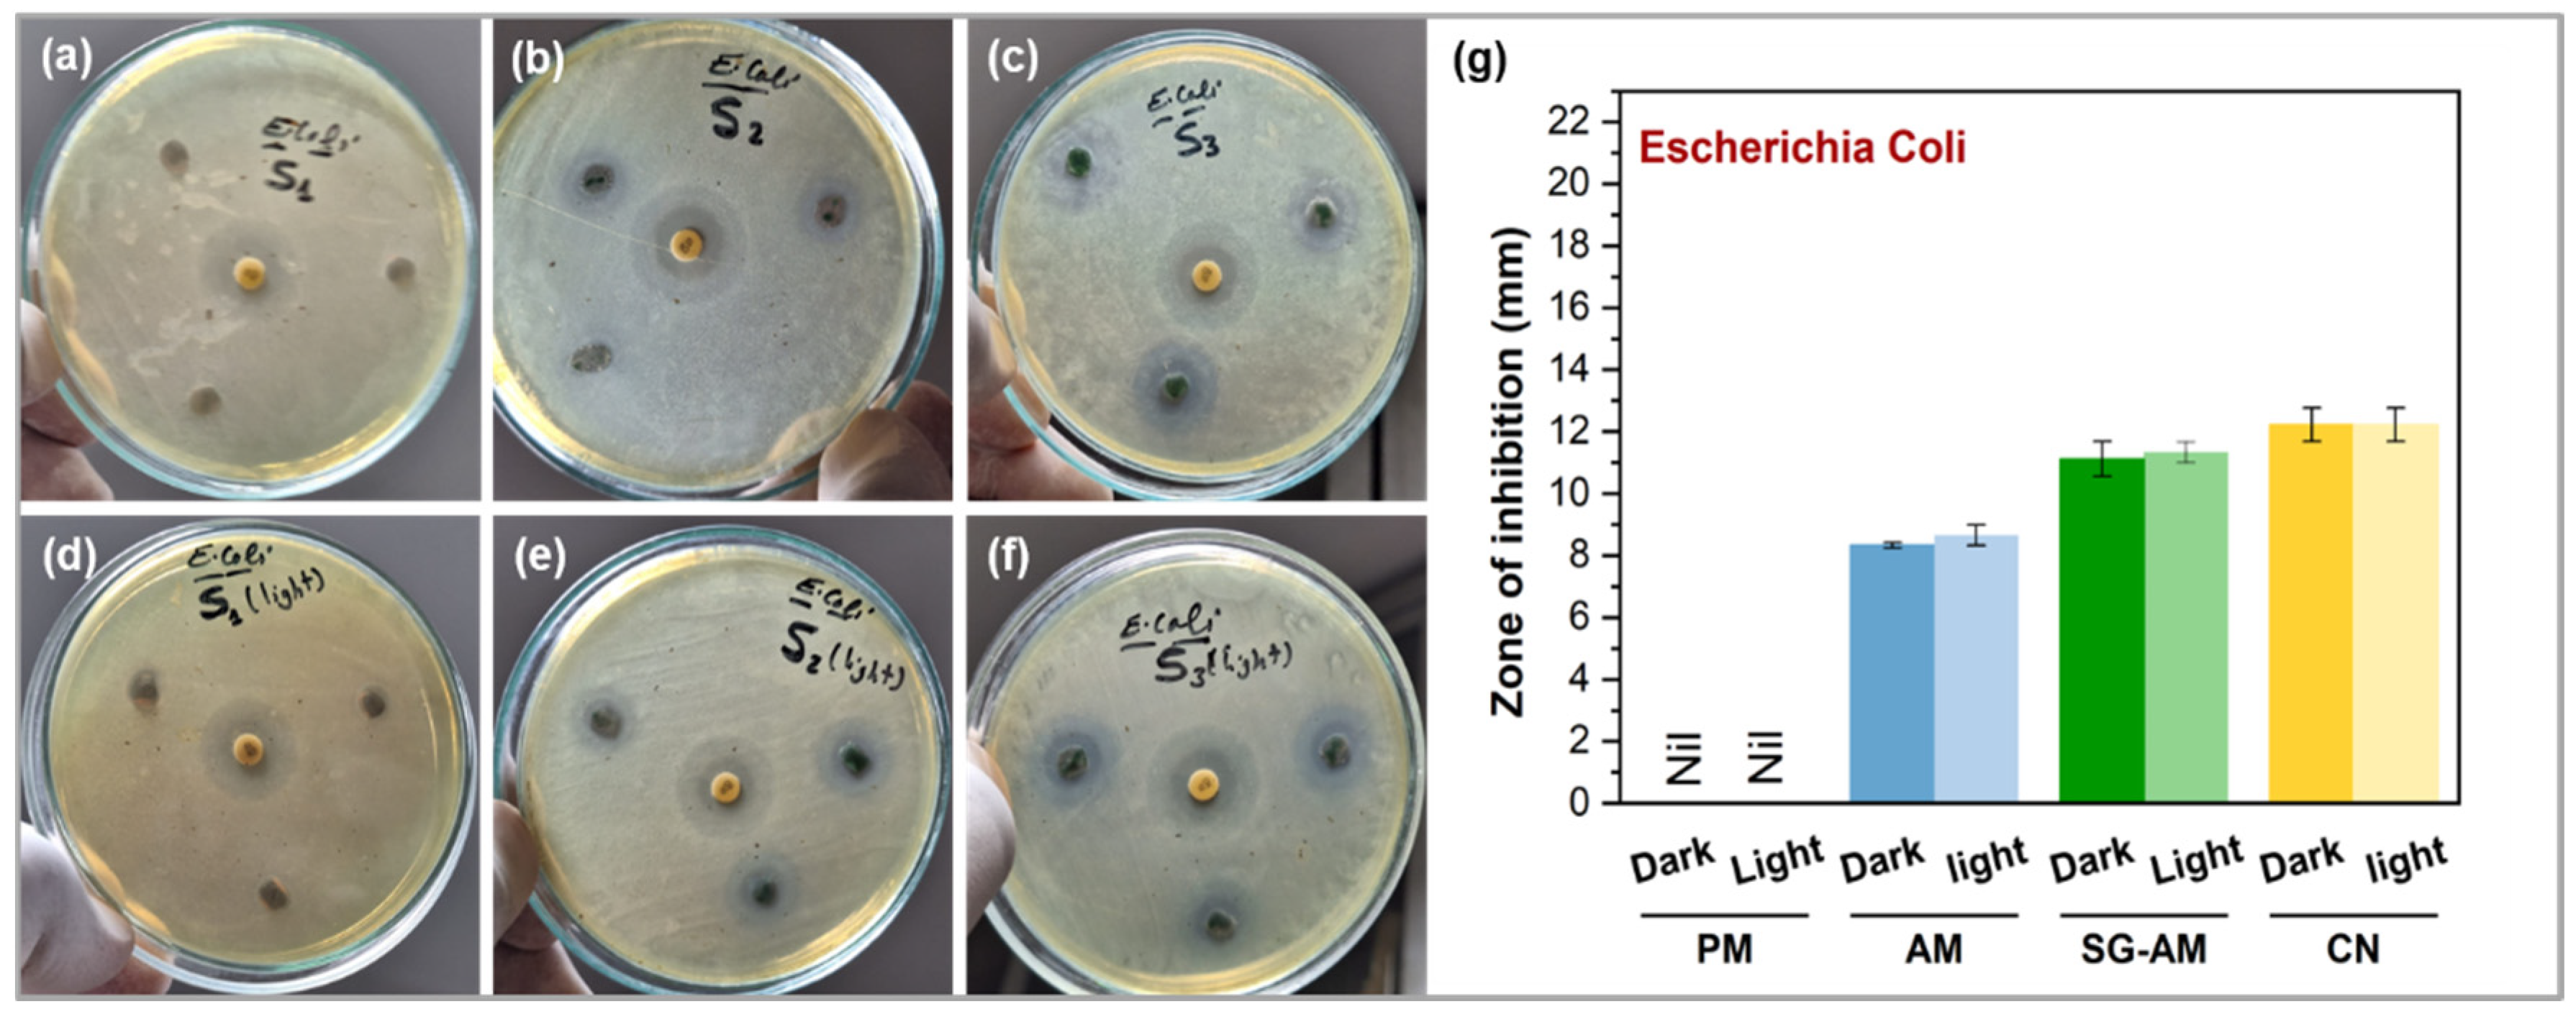
Micro 05 00033 g007

Abstract
Free-standing copper oxide (Cu2O)-copper hydroxide (Cu(OH)2) nanocomposites with enhanced catalytic and antibacterial functionalities were synthesized on copper mesh using a green method based on spinach leaf extract and glycerol. EDX, SEM, and TEM analyses confirmed the chemical composition and morphology. The resulting Cu2O-Cu(OH)2@Cu mesh exhibited notable hydrophobicity, achieving a contact angle of 137.5° ± 0.6, and demonstrated the ability to separate thick oils, such as HD-40 engine oil, from water with a 90% separation efficiency. Concurrently, its photocatalytic performance was evaluated by the degradation of methylene blue (MB) under a weak light intensity of 5 mW/cm2, achieving 85.5% degradation within 30 min. Although its application as a functional membrane in water treatment may raise safety concerns, the mesh showed significant antibacterial activity against both Gram-positive (Staphylococcus aureus) and Gram-negative (Escherichia coli) bacteria under both dark and light conditions. Using the disk diffusion method, strong bacterial inhibition was observed after 24 h of exposure in the dark. Upon visible light irradiation, bactericidal efficiency was further enhanced—by 17% for S. aureus and 2% for E. coli. These findings highlight the potential of the Cu2O-Cu(OH)2@Cu microfibers as a multifunctional membrane for industrial wastewater treatment, capable of simultaneously removing oil, degrading organic dyes, and inactivating pathogenic bacteria through photo-assisted processes.
1. Introduction
According to the 2023 UNESCO report [1], nearly 2 billion people (representing 26% of the global population) still lack access to safe drinking water, with projections indicating a continued rise in water scarcity in the coming years. Ensuring the provision of safe, affordable water to underserved and rural regions necessitates both efficient management of clean water sources and the development of sustainable, multifunctional wastewater treatment solutions. Among emerging strategies for wastewater remediation, advanced oxidation processes (AOPs), have gained significant attention due to their reliance on the generation of highly reactive hydroxyl radicals (•OH), capable of degrading a wide range of pollutants [2]. In particular, photo-assisted AOPs based on photocatalysis offer an effective and economically viable route for treating industrial wastewater [3]. These processes employ semiconductor materials (photocatalysts) that absorb light energy to generate electron–hole pairs, which subsequently facilitate the decomposition of organic dyes into benign byproducts in an environmentally friendly manner [4]. The selection of an effective photocatalyst requires materials with specific properties: a suitable bandgap to absorb visible light, low production cost, recyclability, and compatibility with green synthesis methods. Copper-based compounds such as cuprous oxide (Cu2O), cupric oxide (CuO), and copper hydroxide (Cu(OH)2) fulfill these criteria due to their narrow bandgaps and earth-abundant nature [5]. Moreover, heterogeneous structures formed from two or more copper compounds, such as CuxO@Cu [6,7,8] or CuxO-Cu(OH)2 [9,10], have been shown to enhance photocatalytic performance by promoting the separation and migration of photogenerated charge carriers, hence improving photocatalytic activity.
Oil pollution, whether from accidental leaks or the discharge of edible and industrial oils into aquatic systems, remains a pressing global environmental concern. Among the emerging remediation strategies, membrane filtration using surfaces engineered with tailored wettability has demonstrated considerable potential for the effective treatment of oily wastewater. Hydrophobic porous membranes have been developed from a variety of materials, including metals [11], polymers [12], and fibers [13], each offering unique chemical and structural properties.
In our previous study [14], we successfully synthesized free-standing heterogeneous Cu2O–Cu(OH)2 nanocomposites on copper mesh via a green synthesis route utilizing spinach leaf extract and glycerol. Interestingly, the resulting nanocomposite exhibited a fourfold increase in Cu(OH)2 content relative to Cu2O, achieved without the addition of sodium hydroxide (NaOH), a reagent typically employed to optimize hydroxide ion adsorption [15]. The photocatalytic performance of the green-synthesized Cu2O–Cu(OH)2@Cu mesh was systematically investigated for the degradation of the cationic dye methylene blue (MB), the anionic dye methyl orange (MO), and a mixture of both under both dark and visible light conditions. However, despite these promising photocatalytic results, the mesh’s hydrophobicity and its potential for oil–water separation remained unexplored. Moreover, for its practical application as a multifunctional membrane in water treatment, a thorough investigation of the antibacterial properties of the coated mesh is essential.
Previous studies have shown that the photo-assisted bactericidal activity of copper-based materials is highly dependent on their morphological features, such as particle size [16], and shape [17], as well as their chemical composition [15,18]. In particular, copper nanostructures exhibit superior antibacterial efficacy compared to their microscale counterparts, both in the dark and under light exposure [16]. The superior enhancement of these nanomaterials is primarily attributed to two significant factors: their greater surface area, which increases reactivity, and their enhanced ability to penetrate the pores of bacterial cell walls. Additionally, the surface concentration of Cu(OH)2 plays a critical role in light-assisted antimicrobial activity [15]. Upon photoexcitation, surface hydroxyl groups (–OH) can trap photogenerated holes, leading to the formation of hydroxyl radicals (•OH), which are highly effective in disrupting bacterial cells.
To the best of the authors’ knowledge, the antibacterial potential of heterogeneous Cu2O–Cu(OH)2 nanocomposites synthesized on copper mesh using spinach leaf extract has not been previously investigated. In this study, we aim to utilize the Cu2O/Cu(OH)2@Cu mesh as a multifunctional membrane for simultaneous removal of oil and dye contaminants from water. Furthermore, we evaluate its biocidal activity against two of the most common bacterial strains: Staphylococcus aureus (Gram-positive) and Escherichia coli (Gram-negative), under both dark conditions and visible light irradiation.
2. Materials and Methods
2.1. Synthesis of the Cu2O-Cu(OH)2@Cu Mesh
The green synthesis of the Cu2O-Cu(OH)2@Cu mesh using spinach extract and glycerol was conducted following the procedure previously reported in our earlier work [14]. The specific role of spinach extract and glycerol in facilitating the formation of copper oxide–hydroxide nanocomposites on the copper mesh are discussed in detail in the Supplementary Information (Section S1.1) [19,20]. As illustrated in Figure 1, 100 g of cleaned spinach leaves was boiled in 100 mL of distilled water, and the resulting solution was subjected to a two-step filtration process using Whatman No. 4 filter paper. Commercially available copper mesh (99.99% Cu; Mesh Company, Warrington, UK) was cut into circular pieces of varying diameters depending on the intended application. For photocatalytic and oil–water separation experiments, 4 cm-diameter discs were prepared. For antibacterial testing, 6 mm-diameter discs were produced using a standard paper punch, mimicking the size of standard antibiotic discs (see Figure S1a). All meshes were cleaned ultrasonically in a sequence of 1 M HCl, ethanol, and distilled water. The cleaned mesh samples were then immersed in a mixture of filtered spinach extract and glycerol at a ratio of 3:1 and incubated at 90 °C for 1 h. After treatment, the meshes were removed from the solution and annealed at 200 °C for 1 h in a box furnace (Nabertherm, Lilienthal, Germany). The copper mesh that was treated with spinach extract and glycerol before annealing is referred to as SG-AM. For comparison, two control groups were prepared: pristine copper mesh (PM) and copper mesh annealed at 200 °C without prior treatment (AM), as shown in Figure S1b.

Figure 1.
Schematic illustration of the steps employed to synthesize SG-AM sample (created with BioRender.com).
2.2. Characterization Techniques
The surface morphology and elemental composition of the samples were analyzed using a field emission scanning electron microscope (FESEM, TESCAN VEGA 3, Czech Republic) equipped with energy-dispersive X-ray spectroscopy (EDX) for elemental mapping and analysis. Transmission electron microscopy (TEM, JEOL JEM-2100) was employed to investigate the internal structure and crystallinity of the SG-AM mesh. Fast Fourier Transform (FFT) analysis of the TEM images was conducted using ImageJ software (V 1.53t) to further elucidate the structural features.
2.3. Contact Angle and Oil–Water Separation Measurements
A 5 µL droplet of deionized water was placed on the mesh surface, and an image of the droplet was captured using a magnifying lens. The contact angle was then measured using ImageJ software by analyzing the droplet profile. To evaluate the oil–water separation efficiency, the synthesized mesh was mounted onto the rim of a small glass beaker and secured with two metal clips. HD-40 engine oil (viscosity ≈ 11 cP) was selected as the oil phase for testing. To visually differentiate between the oil and water phases, deionized water was stained with methylene blue (MB) at a concentration of 10 mg/L.
A 1:1 mixture of 5 mL oil and 5 mL dyed water was poured onto the surface of the SG-AM mesh, and the volume of separated oil was collected and measured. The oil–water separation efficiency was calculated using the following equation:
where v1 and v2 represent the volume of oil collected after separation and the initial volume of oil, respectively.
2.4. Photocatalytic Activity Assessment
The MB solution retained on the SG-AM mesh following the oil–water separation process was subsequently utilized to evaluate the photocatalytic dye degradation efficiency. The mesh was then exposed to a white light irradiation using a Xenon Lamp (MAX-303, Asahi Spectra, Nasushiobara, Japan) with an intensity of 5 mW/cm2, simulating solar light conditions. At predefined time intervals, 0.5 mL aliquots were extracted from the solution, and the absorbance was measured using UV–visible spectroscopy at the characteristic wavelength of 665 nm. The dye degradation percentage was calculated using the following equation:
where A0 and At represent the absorbance of the MB solution before and after exposure to light at time t, respectively. The reaction kinetics were calculated according to the first order of the standard linear regression using the following equation:
where k1 (min−1) denotes the first-order rate constant.
2.5. Antibacterial Activity Assessment
The bactericidal activity of the Cu2O-Cu(OH)2@Cu mesh on two pathogenic bacteria, Staphylococcus aureus (ATCC 6538), a Gram-positive bacterium, and Escherichia coli (ATCC 25922), a Gram-negative bacterium, were assessed using the standard disk diffusion method. The growth inhibitory effect of the developed Cu2O-Cu(OH)2@Cu mesh was evaluated by measuring the diameter of the growth inhibition zone. The inoculum size of each pathogenic strain was adjusted to approximately 0.5 McFarland standard, equivalent to 1.5 × 108 CFU/mL.
For each assay, 25.0 µL of the bacterial suspension was evenly spread on sterile nutrient agar (NA) plates (50.0 mL per plate), prepared with a composition of 2 g yeast extract, 5 g peptone, and 5 g NaCl per liter. Following inoculation, the plates were incubated at 37 °C for 24 h. Circular mesh samples (diameter ~6 mm) of pristine mesh (PM), annealed mesh (AM), and green-treated mesh (SG-AM), along with a standard gentamicin antibiotic disc (10 µg), were placed onto the inoculated agar surfaces. After incubation, the diameters of the inhibition zones were measured to quantify antimicrobial activity.
To further investigate the underlying bactericidal mechanism, experiments were conducted under both illuminated and dark conditions. Illumination was provided using a white LED bulb (Sprint, 9 W), and the influence of lighting on antibacterial efficacy was compared across the different treatment groups. All measurements were reported as mean values ± standard error. Statistical analysis was performed using a two-tailed t-test, with significance thresholds set at ** p ≤ 0.01 or * p ≤ 0.05.
3. Results and Discussion
3.1. Structural and Morphological Properties
The successful formation of both Cu2O and Cu(OH)2 phases on the copper mesh was verified using XPS, as reported in our previous work [14]. This green synthesis method involves immersing the Cu mesh in a mixture of spinach extract and glycerol prior to annealing, resulting in a fourfold increase in Cu(OH)2 formation relative to Cu2O on the mesh surface. In contrast, annealing untreated Cu mesh without this green modification leads to a significantly lower Cu(OH)2 yield, approximately half that of CuO and equivalent to that of Cu2O [14].
The EDX spectra of the AM (annealed mesh) and SG-AM (greenly treated and annealed mesh) samples are compared in Figure S2a,b. The EDX spectra confirm that the SG-AM sample predominantly contains copper, carbon, and oxygen, with atomic percentages of 41.5%, 28.1%, and 25.5%, respectively. In contrast, the AM sample exhibits lower carbon and oxygen content. The increased carbon content in the SG-AM sample plays a vital role in enhancing the oxidation of Cu0 to Cu+/Cu2+, facilitates electron transfer, and supports the catalytic decomposition of hydrogen peroxide (H2O2) to generate •OH radicals [21,22].
The morphologies of both the AM and SG-AM samples are depicted in the SEM images shown in Figure 2. In Figure 2a, the diameter of the copper microfibers is approximately 50 µm, while the mesh opening area is approximately 200 µm × 200 µm. This three-dimensional woven substrate can provide a larger specific surface area than a traditional two-dimensional flat substrate, which is expected to improve the accessibility of bacteria to the mesh. Annealing seems to oxidize the surface of the copper microfiber (AM) into a smooth layer of copper oxide, as shown in Figure 2b,c, which contains insignificant shattered particles. Conversely, adding spinach extract and glycerol before annealing produces a rough coating around each copper microfiber, as shown in Figure 2d. With more magnification, the surface of the SG-AM sample appears to consist of nonuniform nanoneedles and merged nanoparticles, as shown in Figure 2e,f. A nanostructured morphology with a larger contact area could offer better utilization of antibacterial activity than bulk structures.

Figure 2.
SEM images at different magnifications of (a–c) the annealed Cu mesh (AM) and (d–f) the green-treated and annealed Cu mesh (SG-AM).
The morphological and structural properties of the SG-AM were further confirmed through transmission electron microscopy (TEM) images and corresponding fast Fourier transform (FFT) measurements. The TEM image in Figure 3a reveals nonuniform nanoparticles with sizes smaller than 100 nm. FFT analysis of the magnified area shown in Figure 3b indicated d-spacing values of 0.27 nm and 0.34 nm (Figure 3c), which correspond to the crystalline planes (021) and (002), respectively, of the orthorhombic Spertiniite Cu(OH)2 mineral (0010212 AMCSD code, 68459 ICSD code). These results are in agreement with the XPS findings [14] and confirm the formation of a copper hydroxide phase on the surface of the SG-AM mesh.

Figure 3.
(a,b) TEM images of the green-treated and annealed Cu mesh (SG-AM) at different magnifications, (c) FFT measurements of image (b).
The angle formed between the surface and the tangent of a water droplet resting on the surface at the air-water interface, as illustrated in Figure 4a, is known as the contact angle. Surfaces exhibiting a water contact angle greater than 90° are classified as hydrophobic [23]. As shown in Figure 4b, the contact angle of pure Cu mesh was calculated to be 130.5° ± 0.6° which is in agreement with a value reported by Mata et al. [24]. However, the contact angle of the Cu mesh heated to 200 °C (AM) was the same as that prepared at room temperature (PM). The obtained value of 130.5° ± 0.5° (Figure 4c) showed that the annealing up to 200 °C did not influence the contact angle. This value is higher than that reported by other studies, where it was found to be 120° [25]. However, as illustrated in Figure 4d, the SG-AM mesh showed the highest contact angle of 137.5° ± 0.6°, which can be attributed to the combined effects of several factors that reduce its surface energy. These include (i) coating with low-surface-energy organic molecules present in the leaf extract; (ii) the formation of nano-scale roughness on the microfibrous structures, as observed in the SEM images; and (iii) the heat treatment, which enhances the adhesion and stability of the organic layer on the copper mesh.

Figure 4.
(a) Schematic drawing symbolizes the method of measuring the contact angle. Photographs of water droplets on the surface of (b) pristine Cu mesh (PM), (c) Cu mesh annealed at 200 °C (AM), and (d) green coated and annealed mesh (SG-AM).
3.2. Water Treatment Application
Based on the contact angle measurements, the SG-AM sample was selected for further evaluation due to its superior hydrophobic properties. This sample was investigated for its dual functionality in both oil–water separation and photocatalytic dye degradation. While the photocatalytic performance of the green-synthesized Cu2O–Cu(OH)2@Cu mesh has been extensively studied in our previous work [14], the current study adopts a novel approach by assessing the mesh’s ability to perform simultaneous oil separation and dye removal. This integrated treatment strategy reflects a more realistic and practical scenario for multifunctional membrane applications in wastewater remediation.
In this experiment, a 1:1 mixture of 5 mL HD-40 engine oil and 5 mL methylene blue–dyed water was poured onto the SG-AM mesh under 5 mW/cm2 white light irradiation, as shown in Figure 5a,b. Owing to the mesh’s hydrophobic nature, water was repelled from the surface, while only the oil phase was able to pass through. At the end of the experiment, the dyed water remained trapped on top of the mesh (Figure 5c), and the separated oil was successfully collected in a container positioned below (Figure 5d). The volume of the collected oil was measured to be 4.5 mL (Figure 5e), yielding an oil–water separation efficiency of 90%, as calculated using Equation (1). his result closely aligns with the findings of Luo et al. [26] who reported a similar efficiency using a superhydrophobic copper mesh coated with PDMS, SiO2 nanoparticles, and a silane coupling agent (KH-550) for Xylene oil separation. A comparative summary of this study and other works utilizing various coatings on Cu mesh is presented in Table S1. It is important to note that the separation efficiency varies significantly depending on the oil’s viscosity and composition. Therefore, for an objective comparison of oil–water separation performance across different studies, both the type and viscosity of the oil must be considered as critical parameters. The HD-40 engine oil used in this work is classified as a highly viscous oil with a viscosity of approximately ~11 cP [27]. For context, lighter oils such as toluene exhibit significantly lower viscosities, with values as low as 0.55 cP [28].

Figure 5.
(a–e) Steps for oil/water separation process for HD-40 engine oil using (SG-AM) mesh. (f) Absorbance peaks, (g) degradation percentage, and (h) kinetic degradation rate of MB over 30 min using (SG-AM) under white light (~5 mW/cm2).
The photocatalytic performance of the SG-AM mesh was subsequently evaluated through the degradation of methylene blue (MB) dye from water retained on the mesh surface (see Figure 5c). The absorbance of the MB solution was measured every 10 min over a total duration of 30 min under a 5 mW/cm2 irradiation to monitor the photodegradation process. As shown in Figure 5f a significant reduction in the absorbance peak at 665 nm was observed, with no notable shift in the peak position, indicating dye degradation without the formation of new chromophoric intermediates. The corresponding degradation efficiency, calculated using Equation (2), reached 85.5%, as illustrated in Figure 5g. The progressive color change of the MB solution during the 30 min irradiation period is displayed in the inset of Figure 5g, visually confirming the extent of degradation. The supposed photocatalytic mechanism of Cu2O-Cu(OH)2 nanocomposites is illustrated in Figure S3 and discussed in detail in (Section S1.2) of the Supplementary Information.
To further analyze the reaction kinetics, the first-order reaction kinetic was conducted according to Equation (3) and the extracted parameters are listed in Table S2. The high correlation coefficient (R2 = 0.9744) indicates an excellent fit of the experimental data to the first-order kinetic mode. As represented in Figure 5h, the corresponding rate constant for the photodegradation process using the SG-AM mesh was calculated to be 0.06261 min−1. This rate is higher than the value previously reported for the same mesh under neutral pH conditions (0.05466 min−1) [14]. The improvement may be attributed to the lower dye volume used in the present study (5 mL) compared to the prior work (30 mL), which likely enhanced the interaction between the dye molecules and the photocatalytically active sites.
When compared to other reported CuxO@Cu composites [7,8,29,30,31,32,33] (see Table S3), the Cu2O–Cu(OH)2@Cu mesh developed in this study demonstrated excellent photocatalytic performance for the degradation of both MB and MO dyes, achieving relatively high reaction rates under low light intensity. This enhanced activity is believed to result, in part, from the natural oxidizing potential of the spinach extract used in the synthesis. Spinach water is known to be rich in hydrogen peroxide (H2O2), a natural oxidant, which may have contributed to the improved photocatalytic behavior and reaction rates under the simulated sunlight. Furthermore, the green synthesis method employed in this work is environmentally friendly and conducive to material recycling, offering both sustainability and practicality. These combined advantages underscore the potential of the Cu2O–Cu(OH)2@Cu mesh as a multifunctional membrane for efficient photocatalytic degradation and oil–water separation.
3.3. Antibacterial Activity Against S. aureus
The antibacterial activities of the PM, AM, and SG-AM meshes were investigated against S. aureus (a Gram-positive bacterial strain) under both dark conditions and under visible light. Figure 6a–f shows images of the inhibition zones for all three samples, highlighting their effect on S. aureus with and without visible irradiation. The inhibition zone diameters were measured with precision, focusing exclusively on the darker regions corresponding to complete bacterial clearance, while partially inhibited areas at the periphery were excluded from analysis. The quantified inhibition zone diameters are displayed in Figure 6g. In the absence of light, SG-AM achieved an inhibition zone diameter of 16.59 ± 0.61 mm, surpassing that of the AM sample (14.44 ± 1.11 mm), while the pristine mesh (PM) showed no measurable inhibition. Upon exposure to visible light, the antibacterial performance of SG-AM further improved, reaching an inhibition zone of 19.41 ± 1.02 mm, an enhancement of approximately 17%. This value exceeded the zone produced by the standard gentamicin antibiotic disc (17.69 ± 0.49 mm), which remained unaffected by light exposure. Compared to the pristine Cu mesh (PM), the CuxO-Cu(OH)2@Cu mesh (SG-AM) exhibited significantly enhanced antibacterial activity against S. aureus under both light and dark conditions (p ≤ 0.05).
Figure 6.
Inhibition zones toward S. aureus for all three samples (a–c) in the dark and (d–f) under illumination. (g) Bar chart showing the zone of inhibition for each sample compared to Gentamicin 10 mcg standard antibiotic disc as a control (CN).
The superior performance of SG-AM under visible light can be attributed to its photocatalytic nature. Copper oxide–hydroxide nanocomposites such as CuxO-Cu(OH)2 can absorb photons in the visible range, initiating photoinduced electron transfer processes at their surface. These reactions lead to the formation of reactive oxygen species (ROS), including •OH and •O2-, or strong oxidants such as H2O2, all of which contribute to bacterial inactivation through oxidative damage and bacterial inactivation [15]. These photogenerated species can penetrate and disrupt bacterial cell membranes, ultimately resulting in cell death.
Additionally, the nanoneedle-like morphology observed on the surface of the SG-AM mesh (Figure 2f) may further enhance its antibacterial efficacy. The sharp edges of these nanostructures can physically damage bacterial membranes upon contact—a mechanism supported by previous studies [17,18,34]. Consequently, CuxO-Cu(OH)2 nanocomposites on woven Cu meshes can be considered a promising antibacterial material against Gram bacteria, such as S. aureus, both in the dark and under visible light illumination.
3.4. Antibacterial Activity Against E. coli
Among the negative Gram bacteria (E. coli), the growth inhibition effect of the CuxO-Cu(OH)2@Cu mesh was relatively low. Photos of the inhibition zones obtained in this case are presented in Figure 7a–f. The diameters of the growth inhibition zones for all the tested samples against E. coli were measured and are plotted in Figure 7g.

Figure 7.
Inhibition zones toward E. coli for all three samples (a–c) in the dark and (d–f) under illumination. (g) Bar chart showing the zone of inhibition for each sample compared to Gentamicin 10 mcg standard antibiotic disc as a control (CN).
In contrast to the pristine Cu mesh (PM), which exhibited no observable antibacterial activity against E. coli, the oxide sample (AM) demonstrated moderate efficacy, presenting an inhibition zone of 8.33 ± 0.09 mm under dark conditions. Notably, the oxide–hydroxide mesh (SG-AM) exhibited an enhanced bactericidal effect, achieving an inhibition zone of 11.11 ± 0.56 mm, which is comparable to that produced by the standard antibiotic control disc (12.22 ± 0.55 mm). Upon exposure to visible light, the SG-AM sample showed a slight increase in inhibition zone diameter to 11.34 ± 0.33 mm. Nevertheless, it exhibited a statistically significant improvement in antibacterial activity compared to AM under both dark (p < 0.03) and light (p < 0.004) conditions. Furthermore, in comparison to the pristine Cu mesh (PM), the SG-AM mesh demonstrated significantly enhanced antibacterial activity against E. coli under both lighting conditions (p ≤ 0.01). These findings highlight the superior antibacterial performance of the SG-AM nanocomposite, particularly under light-enhanced conditions.
The observed differences in the antibacterial activity of SG-AM sample against E. coli and S. aureus are consistent with prior studies [16,18,34], which attribute such variations to the structural differences in the bacterial cell walls. E. coli, a Gram-negative bacterium, possesses a dual-membrane structure with a thin peptidoglycan layer sandwiched between an inner cytoplasmic membrane and a robust outer lipid membrane. This outer membrane acts as a formidable barrier against oxidative stress and external antimicrobial agents [35]. In contrast, S. aureus, a Gram-positive bacterium, lacks this outer membrane and instead features a thick peptidoglycan wall that, despite its rigidity, offers less protection against oxidative or chemical damage, rendering it more susceptible to bactericidal materials such as the SG-AM nanocomposite [16].
Table 1 summarizes the antibacterial performance of the PM, AM, and SG-AM meshes against S. aureus and E. coli both in the dark and under visible light. It has been reported in literature that green-synthesized CuO NPs exhibit potent antimicrobial activity through diverse mechanisms, including disrupting microbial membranes, interfering with microbial enzymes, releasing copper ions (Cu2+), and generating reactive oxygen species [36].

Table 1.
Inhibition zones for all three samples toward S. aureus and E. coli in the dark and under illumination. The results are compared to Gentamicin 10 mcg standard antibiotic disc as a control (CN). The measured inhibition zone is repeated three times (n = 3) and represented as mean ± SD. (*) and (**) represent the significant difference at (p ≤ 0.05) and (p ≤ 0.01), respectively, compared to PM mesh.
The antibacterial performance of the synthesized samples was compared against previously reported Cu-based nanomaterials, as summarized in Table S4. To ensure a valid comparison, only studies employing the inhibition zone method with a standardized active disc diameter of 6 mm were considered. For these reasons, results from Schio et al. [16] and Akhavan et al. [15] were excluded, as those studies utilized the drop diffusion method, which differs in mechanism and measurement criteria. Bilal et al. [34] investigated the antibacterial efficacy of CuO nanostructures doped with chitosan-grafted polyacrylic acid (CS-g-PAA), revealing enhanced bactericidal activity with increasing dopant concentration. At 6% doping, inhibition zones against S. aureus ranged from 6.15 to 8.15 mm, while those against E. coli spanned 4.20 to 5.25 mm, depending on the applied dose. Similarly, Priya et al. [37] synthesized CuO nanoparticles using Morinda citrifolia leaf extract and reported potent antibacterial activity, yielding inhibition zones of 13.2 ± 0.2 mm for S. aureus and 13.1 ± 1.2 mm for E. coli. Recently, Huong et al. [38] examined CuO-decorated ZnO heterojunction nanocomposites, demonstrating inhibition zones of 12.8 mm and 12.4 mm against S. aureus and E. coli, respectively, under dark conditions. Upon white light illumination, the bactericidal efficacy improved by 16.4% and 17.7% for S. aureus and E. coli, respectively, indicating the photocatalytic enhancement of antibacterial activity in the CuO-ZnO system.
The slight variations in inhibition zone diameters reported in Table S4 can largely be attributed to differences in the concentrations of the antibacterial agents employed, categorized as low (L) or high (H). Unlike powder-based formulations where precise dosing is feasible, our study utilized a mesh-supported nanocomposite, inherently limiting control over the material’s applied concentration. Despite this, the antibacterial efficacy of our Cu2O–Cu(OH)2 mesh under dark conditions was comparable to that of high-concentration powder-based systems. Furthermore, the light-responsive nature of our nanocomposite enabled enhanced antibacterial activity under visible light irradiation, without requiring any modifications to the material or additional external stimuli.
4. Conclusions
In conclusion, heterogeneous Cu2O–Cu(OH)2 nanocomposites were successfully synthesized on Cu mesh via a simple, cost-effective, and environmentally friendly approach utilizing spinach leaf extract and glycerol as green reducing agents. The resulting Cu2O–Cu(OH)2@Cu mesh, annealed at 200 °C, exhibited multifunctional performance, including efficient oil–water separation and notable removal of methylene blue (MB) dye from aqueous solutions. Additionally, the nanocomposite demonstrated strong antibacterial activity against both S. aureus and E. coli, under both dark conditions and visible light irradiation. These findings highlight the critical role of hydroxide groups in enhancing bactericidal efficacy by disrupting the structural integrity of bacterial membranes, offering a promising route for sustainable membrane-based water treatment applications.
5. Patents
This study is an extension of our previous work that was patented on the 5 July 2022 from USPTO-Patent number: US11376570.
Supplementary Materials
The following supporting information can be downloaded at https://www.mdpi.com/article/10.3390/micro5030033/s1, Figure S1: Images illustrate (a) diameter of punched circles and (b) final look of our three samples; Figure S2: EDX spectra and their tables of element mass and atom percentages of (a) the only annealed Cu mesh (AM) and (b) the green-treated and annealed Cu mesh (SG-AM); Table S1: Brief comparison between our results and other reported hydrophobic Cu mesh for oil/water separation; Table S2: Linear regression analysis for sample (SG-AM) based on first-order model reaction kinetics; Table S3: Brief comparison between our results and other reported CuxO@Cu composites; Table S4: Brief comparison between the antibacterial performance of our samples and other reported studies.
Author Contributions
Methodology and Writing—Original Draft, H.A.-J.; Investigation, Data Curation, and Validation, N.A.A., R.A., and L.A.; Visualization and Resources, R.S.; Conceptualization, Writing—Reviewing and Editing, N.A.-A. and N.E. All authors provided critical feedback and helped shape the research, analysis and manuscript. All authors have read and agreed to the published version of the manuscript.
Funding
This research received no external funding.
Institutional Review Board Statement
Not applicable.
Informed Consent Statement
Not applicable.
Data Availability Statement
The data of this study are available from the corresponding author upon reasonable request.
Conflicts of Interest
On behalf of all the authors, the corresponding author states that there are no conflicts of interest regarding the publication of this article.
References
- UNESCO. Imminent Risk of a Global Water Crisis, Warns the UN World Water Development Report 2023. Pressed on 22 March 2023. Available online: https://www.unesco.org/en/articles/imminent-risk-global-water-crisis-warns-un-world-water-development-report-2023 (accessed on 2 July 2025).
- Khan, S.; Sayed, M.; Sohail, M.; Shah, L.A.; Raja, M.A. Chapter 6—Advanced Oxidation and Reduction Processes. In Advances in Water Purification Techniques; Ahuja, S., Ed.; Elsevier: Amsterdam, The Netherlands, 2019; pp. 135–164. [Google Scholar]
- Sadeghfar, F.; Ghaedi, M.; Zalipour, Z. Chapter 4—Advanced oxidation. In Interface Science and Technology; Ghaedi, M., Ed.; Elsevier: Amsterdam, The Netherlands, 2021; Volume 32, pp. 225–324. [Google Scholar]
- Dong, S.; Feng, J.; Fan, M.; Pi, Y.; Hu, L.; Han, X.; Liu, M.; Sun, J.; Sun, J. Recent developments in heterogeneous photocatalytic water treatment using visible light-responsive photocatalysts: A review. RSC Adv. 2015, 5, 14610–14630. [Google Scholar] [CrossRef]
- Meyer, B.K.; Polity, A.; Reppin, D.; Becker, M.; Hering, P.; Klar, P.J.; Sander, T.; Reindl, C.; Benz, J.; Eickhoff, M.; et al. Binary copper oxide semiconductors: From materials towards devices. Phys. Status Solidi B 2012, 249, 1487–1509. [Google Scholar] [CrossRef]
- Sun, S. Recent advances in hybrid Cu2O-based heterogeneous nanostructures. Nanoscale 2015, 7, 10850–10882. [Google Scholar] [CrossRef] [PubMed]
- Al-Jawhari, H.; Al-Murashi, R.; Abu Saba, L.; Alhebshi, N.; Altuwirqi, R. Effective degradation of MB under natural daylight using green synthesized Cu-Cu2O composite films. Mater. Lett. 2019, 254, 233–236. [Google Scholar] [CrossRef]
- Alhebshi, N.; Huang, H.; Ghandour, R.; Alghamdi, N.K.; Alharbi, O.; Aljurban, S.; He, J.-H.; Al-Jawhari, H. Green synthesized CuxO@Cu nanocomposites on a Cu mesh with dual catalytic functions for dye degradation and hydrogen evaluation. J. Alloys Compd. 2020, 848, 156284. [Google Scholar] [CrossRef]
- Murugadoss, G.; Rajesh Kumar, M.; Kuppusami, P. Synthesis of Cu2O-Cu(OH)2 nanocomposite from CuSCN precursor by a facile chemical precipitation method. Mater. Lett. 2021, 284, 128866. [Google Scholar] [CrossRef]
- Hu, L.; Wang, Z.; Hu, Y.; Liu, Y.; Zhang, S.; Zhou, Y.; Zhang, Y.; Liu, Y.; Li, B. The preparation of Janus Cu(OH)2@Cu2O/Cu mesh and application in purification of oily wastewater. Mater. Res. Bull. 2020, 126, 110815. [Google Scholar] [CrossRef]
- Ye, S.; Cao, Q.; Wang, Q.; Wang, T.; Peng, Q. A highly efficient, stable, durable, and recyclable filter fabricated by femtosecond laser drilling of a titanium foil for oil-water separation. Sci. Rep. 2016, 6, 37591. [Google Scholar] [CrossRef]
- Zhang, W.; Shi, Z.; Zhang, F.; Liu, X.; Jin, J.; Jiang, L. Superhydrophobic and superoleophilic PVDF membranes for effective separation of water-in-oil emulsions with high flux. Adv. Mater. 2013, 25, 2071–2076. [Google Scholar] [CrossRef]
- Zhang, J.; Seeger, S. Polyester Materials with Superwetting Silicone Nanofilaments for Oil/Water Separation and Selective Oil Absorption. Adv. Funct. Mater. 2011, 21, 4699–4704. [Google Scholar] [CrossRef]
- Al-Jawhari, H.A.; Alhebshi, N.A. Green Synthesized Cu2O-Cu(OH)2@Cu Nanocomposites with Fenton-like Catalytic Properties for the Degradation of Cationic and Anionic Dyes. Crystals 2022, 12, 1328. [Google Scholar] [CrossRef]
- Akhavan, O.; Azimirad, R.; Safa, S.; Hasani, E. CuO/Cu(OH)2 hierarchical nanostructures as bactericidal photocatalysts. J. Mater. Chem. 2011, 21, 9634–9640. [Google Scholar] [CrossRef]
- Schio, A.L.; de Lima, M.S.; Frassini, R.; Scariot, F.J.; Cemin, F.; Elois, M.A.; Alvarez, F.; Michels, A.F.; Fongaro, G.; Roesch-Ely, M.; et al. Light, Copper, Action: Visible-Light Illumination Enhances Bactericidal Activity of Copper Particles. ACS Biomater. Sci. Eng. 2024, 10, 1808–1818. [Google Scholar] [CrossRef] [PubMed]
- Xiong, L.; Tong, Z.-H.; Chen, J.-J.; Li, L.-L.; Yu, H.-Q. Morphology-dependent antimicrobial activity of Cu/CuxO nanoparticles. Ecotoxicology 2015, 24, 2067–2072. [Google Scholar] [CrossRef]
- Hoseinnejad, M.; Jafari, S.M.; Katouzian, I. Inorganic and metal nanoparticles and their antimicrobial activity in food packaging applications. Crit. Rev. Microbiol. 2018, 44, 161–181. [Google Scholar] [CrossRef]
- Zheng, J.Y.; Van, T.-K.; Pawar, A.U.; Kim, C.W.; Kang, Y.S. One-step transformation of Cu to Cu2O in alkaline solution. RSC Adv. 2014, 4, 18616–18620. [Google Scholar] [CrossRef]
- Liu, Y.; Chu, Y.; Li, M.; Li, L.; Dong, L. In situ synthesis and assembly of copper oxide nanocrystals on copper foil via a mild hydrothermal process. J. Mater. Chem. 2006, 16, 192–198. [Google Scholar] [CrossRef]
- Sun, B.; Li, H.; Li, X.; Liu, X.; Zhang, C.; Xu, H.; Zhao, X.S. Degradation of Organic Dyes over Fenton-Like Cu2O–Cu/C Catalysts. Ind. Eng. Chem. Res. 2018, 57, 14011–14021. [Google Scholar] [CrossRef]
- Zhu, G.; Jin, Y.; Ge, M. Simple and green method for preparing copper nanoparticles supported on carbonized cotton as a heterogeneous Fenton-like catalyst. Colloids Surf. A Physicochem. Eng. Asp. 2022, 647, 128978. [Google Scholar] [CrossRef]
- Crick, C.R.; Parkin, I.P. Preparation and characterisation of super-hydrophobic surfaces. Chemistry 2010, 16, 3568–3588. [Google Scholar] [CrossRef]
- Mata, A.; Fleischman, A.J.; Roy, S. Characterization of polydimethylsiloxane (PDMS) properties for biomedical micro/nanosystems. Biomed. Microdevices 2005, 7, 281–293. [Google Scholar] [CrossRef] [PubMed]
- Singh, V.; Sheng, Y.-J.; Tsao, H.-K. Facile fabrication of superhydrophobic copper mesh for oil/water separation and theoretical principle for separation design. J. Taiwan Inst. Chem. Eng. 2018, 87, 150–157. [Google Scholar] [CrossRef]
- Luo, Z.; Li, Y.; Duan, C.; Wang, B. Fabrication of a superhydrophobic mesh based on PDMS/SiO2 nanoparticles/PVDF microparticles/KH-550 by one-step dip-coating method. RSC Adv. 2018, 8, 16251–16259. [Google Scholar] [CrossRef] [PubMed]
- Al-Rehaili, L.J.; Altuwirqi, R.M.; Aljarb, A.A.; Al-Jawhari, H.A. A superhydrophobic graphene@copper mesh irradiated by laser for efficient oil/water separation. Surf. Coat. Technol. 2023, 463, 129495. [Google Scholar] [CrossRef]
- Yu, Z.-P.; Zhan, B.; Dong, L.-M.; Jiang, W.; Song, Y.-Y.; Hu, S.-A. Self-Healing Structured Graphene Surface with Reversible Wettability for Oil–Water Separation. ACS Appl. Nano Mater. 2019, 2, 1505–1515. [Google Scholar] [CrossRef]
- Li, H.; Su, Z.; Hu, S.; Yan, Y. Free-standing and flexible Cu/Cu2O/CuO heterojunction net: A novel material as cost-effective and easily recycled visible-light photocatalyst. Appl. Catal. B 2017, 207, 134–142. [Google Scholar] [CrossRef]
- Baghriche, O.; Rtimi, S.; Pulgarin, C.; Kiwi, J. Polystyrene CuO/Cu2O uniform films inducing MB-degradation under sunlight. Catal. Today 2017, 284, 77–83. [Google Scholar] [CrossRef]
- Mousavi-Kamazani, M.; Zarghami, Z.; Rahmatolahzadeh, R.; Ramezani, M. Solvent free synthesis of Cu-Cu2O nanocomposites via green thermal decomposition route. Adv. Powder Technol. 2017, 28, 2078–2086. [Google Scholar] [CrossRef]
- Xu, L.; Srinivasakannan, C.; Peng, J.; Zhang, L.; Zhang, D. Synthesis of Cu-CuO nanocomposite in microreactor and its application to photocatalytic degradation. J. Alloys Compd. 2017, 695, 263–269. [Google Scholar] [CrossRef]
- Jiang, D.; Xue, J.; Wu, L.; Zhou, W.; Zhang, Y.; Li, X. Photocatalytic performance enhancement of CuO-Cu2O heterostructures for photodegradation of organic dyes- Effects of CuO morphology. Appl. Catal. B 2017, 211, 199–204. [Google Scholar] [CrossRef]
- Bilal, M.; Ikram, M.; Shujah, T.; Haider, A.; Naz, S.; Ul-Hamid, A.; Naz, M.; Haider, J.; Shahzadi, I.; Nabgan, W. Chitosan-Grafted Polyacrylic Acid-Doped Copper Oxide Nanoflakes Used as a Potential Dye Degrader and Antibacterial Agent: In Silico Molecular Docking Analysis. ACS Omega 2022, 7, 41614–41626. [Google Scholar] [CrossRef] [PubMed]
- Breijyeh, Z.; Jubeh, B.; Karaman, R. Resistance of Gram-Negative Bacteria to Current Antibacterial Agents and Approaches to Resolve It. Molecules 2020, 25, 1340. [Google Scholar] [CrossRef] [PubMed]
- Gebreslassie, Y.T.; Gebremeskel, F.G. Green and cost-effective biofabrication of copper oxide nanoparticles: Exploring antimicrobial and anticancer applications. Biotechnol. Rep. 2024, 41, e00828. [Google Scholar] [CrossRef] [PubMed]
- Priya, M.; Venkatesan, R.; Deepa, S.; Sana, S.S.; Arumugam, S.; Karami, A.M.; Vetcher, A.A.; Kim, S.-C. Green synthesis, characterization, antibacterial, and antifungal activity of copper oxide nanoparticles derived from Morinda citrifolia leaf extract. Sci. Rep. 2023, 13, 18838. [Google Scholar] [CrossRef]
- Huong, L.M.; Nam, N.T.H.; Dat, N.T.; Dat, N.M.; Cong, C.Q.; Ngan, L.T.; Ngan, H.T.K.; An, H.; Tai, L.T.; Hung, P.N.P.; et al. Antibacterial mechanism of phyto-synthesized CuO-decorated ZnO nanostructure in relation to hydrogen peroxide generation under visible-light condition. Surf. Interfaces 2023, 40, 102988. [Google Scholar] [CrossRef]
Disclaimer/Publisher’s Note: The statements, opinions and data contained in all publications are solely those of the individual author(s) and contributor(s) and not of MDPI and/or the editor(s). MDPI and/or the editor(s) disclaim responsibility for any injury to people or property resulting from any ideas, methods, instructions or products referred to in the content. |
© 2025 by the authors. Licensee MDPI, Basel, Switzerland. This article is an open access article distributed under the terms and conditions of the Creative Commons Attribution (CC BY) license (https://creativecommons.org/licenses/by/4.0/).